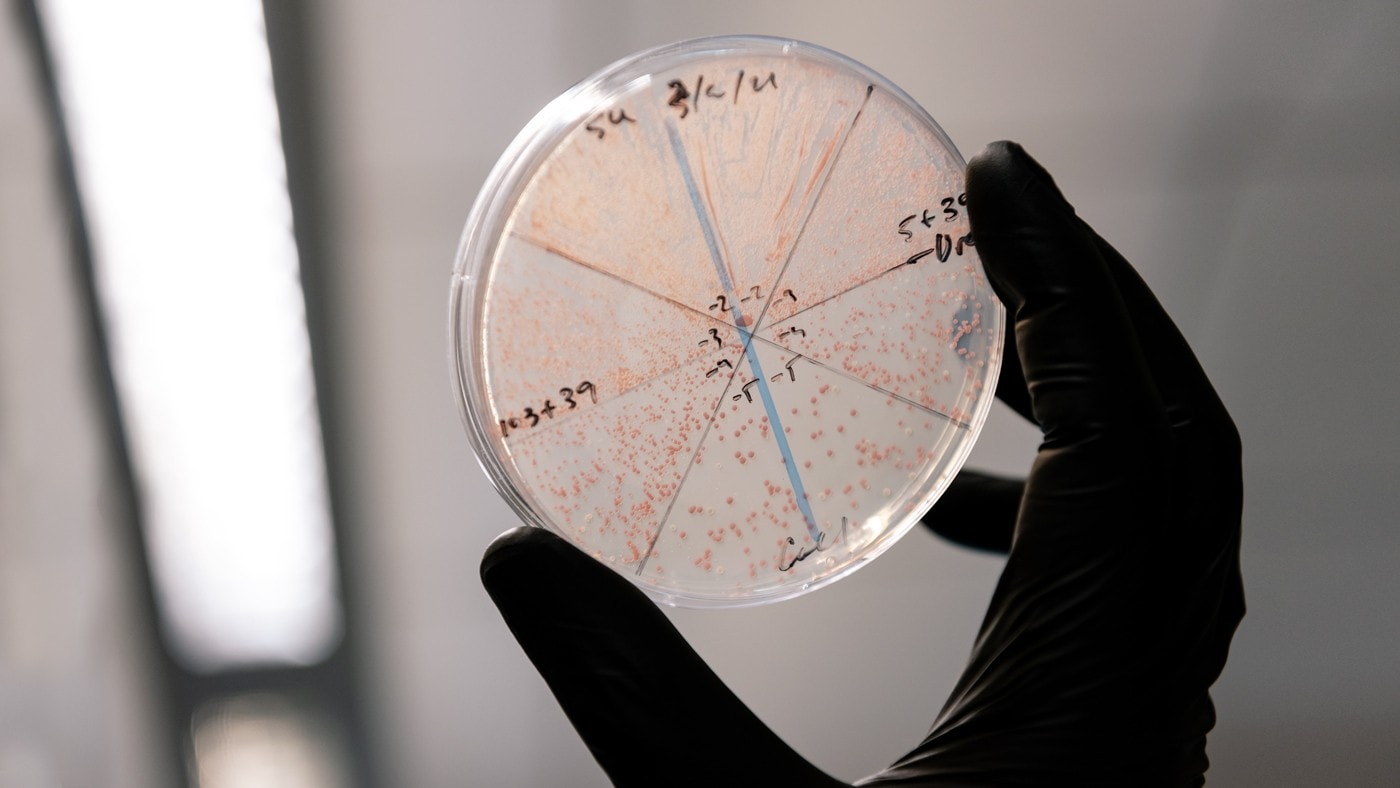
Retrony pozwolą na genetyczne “cuda”

Większość istniejących technik edycji genów – z CRISPR na czele – polega na wycięciu fragmentu DNA z genomu, a następnie wprowadzeniu w jego miejsce “prawidłowego” odcinka zwanego szablonowym DNA. Komórka regeneruje się i wbudowuje wprowadzony fragment. Szablonowe DNA zazwyczaj wytwarza się w warunkach laboratoryjnych, a białkiem, które dokonuje genetycznego cięcia jest kaspaza 9 (Cas9). Żaden z elementów tego systemu nie przenika do każdej komórki, co ogranicza jej efektywność.
Czytaj też: Edycja genomu w kosmosie to już rzeczywistość. Astronauci użyli metody CRISPR/Cas9
Z kolei retrony to miniaturowe fabryki DNA, które samoistnie wytwarzają liczne kopie szablonowego DNA. Retrony można stosować razem z techniką CRISPR, co pozwala naukowcom śledzić dokonane zmiany.
Do każdej komórki musimy wprowadzić tylko jeden element. To znacznie upraszcza proces i otwiera drzwi dla nowych typów eksperymentów.Santiago Lopez, student z Gladstone Institutes, główny autor pracy
Jak przeprojektować retrony?
Zarówno CRISPR, jak i retrony to mechanizmy obronne wykorzystywane przez bakterie do odpowiedzi na infekcje. To z kolei oznacza, że oba systemy można ulepszyć. W nowym badaniu, zespół dr Setha Shipmana z Gladstone Institutes zmodyfikował retrony bakterii E.coli, aby stworzyć setki nowych wariantów. To doprowadziło do 8-10-krotnego wzrostu ilości szablonowego DNA.
Nowy system retronowy został przetestowany na drożdżach piekarskich (Saccharomyces cerevisiae) oraz na hodowlanych komórkach ludzkich. Okazało się, że nowa technika jest wyjątkowo skuteczna. Było to pierwsze w historii zastosowanie techniki retronów na ludzkich komórkach.
Nasze badania po raz pierwszy pokazują, że im więcej szablonowego DNA możemy wyprodukować, tym lepsza jest edycja genomu. Lepsza i bardziej precyzyjna edycja ostatecznie oznacza skuteczniejsze i bezpieczniejsze leki genomowe oraz bardziej zaawansowane badania podstawowe.dr Seth Shipman
Retrony są dostępne jako narzędzie badawcze do edycji genów w różnych typach komórek w warunkach laboratoryjnych. Chociaż platforma ta nie jest jeszcze gotowa do wykorzystania u ludzi, ma potencjał, aby pomóc w edycji genów w celach terapeutycznych.